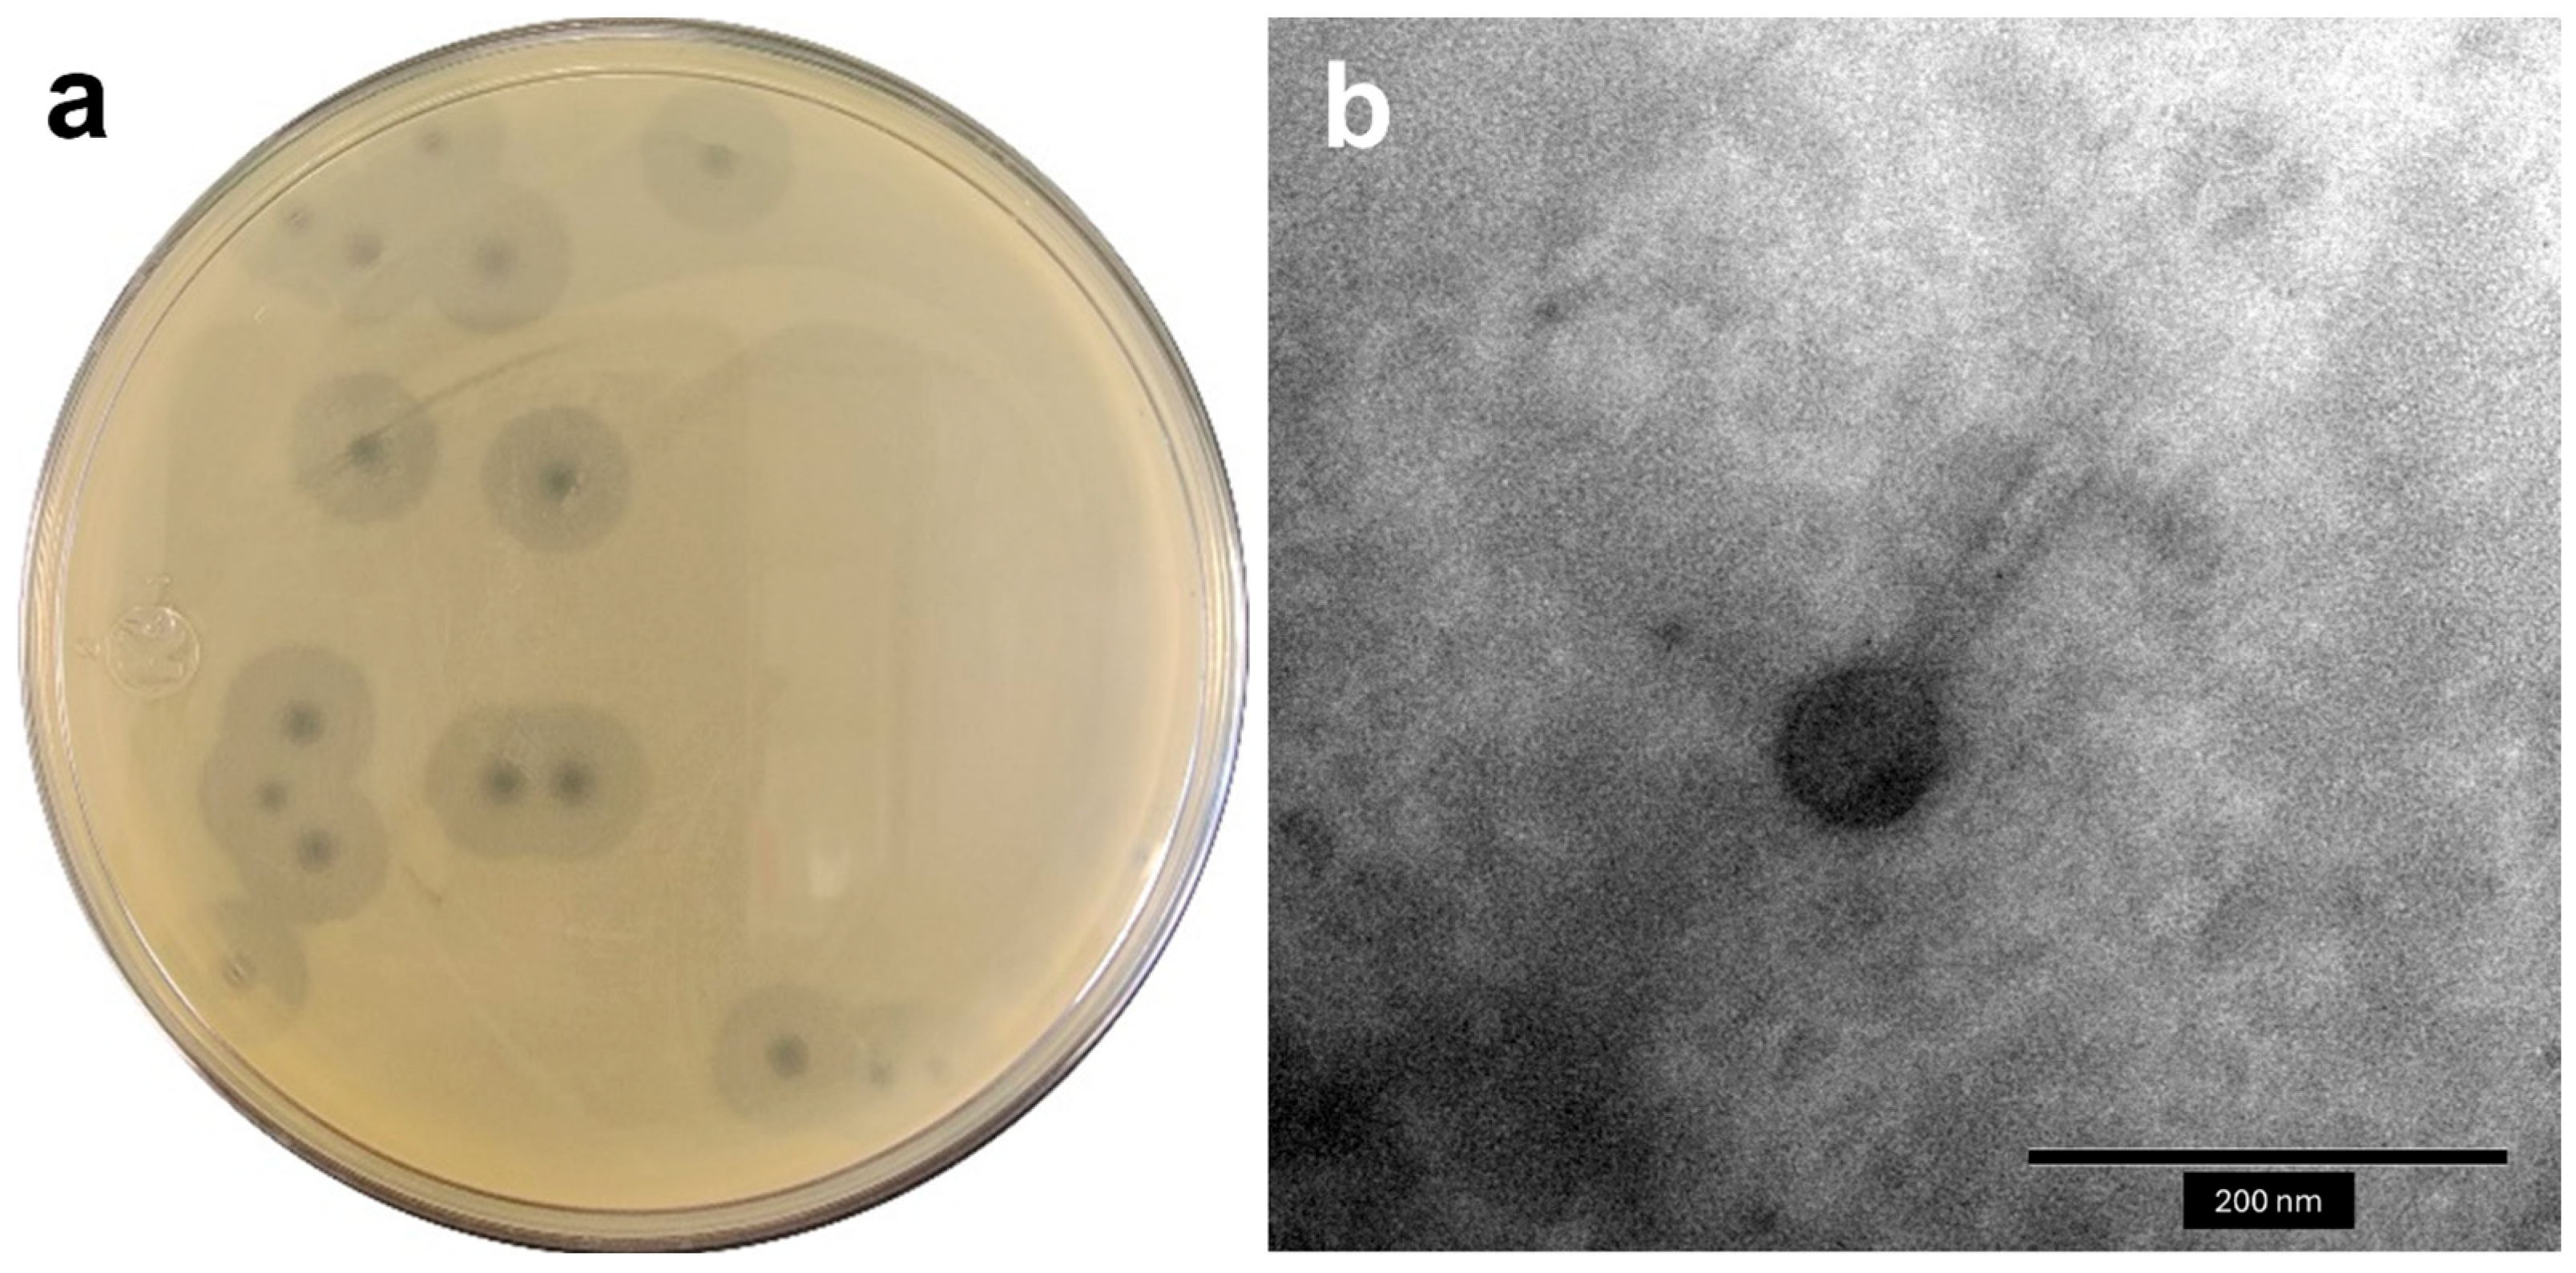
Antibiotics 14 00961 g001

A Newly Discovered Obolenskvirus Phage with Sustained Lytic Activity Against Multidrug-Resistant Acinetobacter baumannii
Abstract
1. Introduction
2. Results
2.1. Isolation and General Features of Phages
2.2. Host Range Analysis and Efficacy of Plating (EOP)
2.3. Physiological Characterization
2.4. Bacteriolytic Activity
2.5. Genome Sequencing and Bioinformatic Analysis
3. Discussion
4. Materials and Methods
4.1. Biological Material
4.2. Phage Isolation and Transmission Electron Microscopy
4.3. Host Range and Efficiency of Plating
4.4. Stability Assays: Temperature and pH
4.5. One-Step Growth Curve
4.6. Bacteriolytic Activity
4.7. DNA Extraction and Genome Sequencing
4.8. Bioinformatic Analyses
4.9. Statistical Analysis
5. Conclusions
Supplementary Materials
Author Contributions
Funding
Institutional Review Board Statement
Informed Consent Statement
Data Availability Statement
Acknowledgments
Conflicts of Interest
References
- Urban-Chmiel, R.; Marek, A.; Stępień-Pyśniak, D.; Wieczorek, K.; Dec, M.; Nowaczed, A.; Osek, J. Antibiotic Resistance in Bacteria—A Review. Antibiotics 2022, 11, 1079. [Google Scholar] [CrossRef]
- Jiménez-Pearson, M.A.; Galas, M.; Corso, A.; Hormazábal, J.C.; Duarte Valderrama, C.; Salgado Marcano, N.; Ramón-Pardo, P.; Melano, R.G. Consenso latinoamericano para definir, categorizar y notificar patógenos multirresistentes, con resistencia extendida o panresistentes. Rev. Panam. Salud Pública 2019, 43, e65. [Google Scholar] [CrossRef]
- Magiorakos, A.P.; Srinivasan, A.; Carey, R.B.; Carmeli, Y.; Falagas, M.E.; Giske, C.G.; Harbarth, S.; Hindler, J.F.; Kahlmeter, G.; Olsson-Liljequist, B.J.C.M.; et al. Multidrug-resistant, extensively drug-resistant and pandrug-resistant bacteria: An international expert proposal for interim standard definitions for acquired resistance. Clin. Microbiol. Infect. 2012, 18, 268–281. [Google Scholar] [CrossRef]
- Lin, D.M.; Koskella, B.; Lin, H.C. Phage therapy: An alternative to antibiotics in the age of multi-drug resistance. World J. Gastrointest. Pharmacol. Ther. 2017, 8, 162–173. [Google Scholar] [CrossRef] [PubMed]
- WHO. WHO Bacterial Priority Pathogens List, 2024: Bacterial Pathogens of Public Health Importance to Guide Research, Development and Strategies to Prevent and Control Antimicrobial Resistance; World Health Organization: Geneva, Switzerland, 2024. [Google Scholar]
- Pendleton, J.N.; Gorman, S.P.; Gilmore, B.F. Clinical relevance of the ESKAPE pathogens. Expert Rev. Anti-Infect. Ther. 2013, 11, 297–308. [Google Scholar] [CrossRef] [PubMed]
- Boucher, H.W.; Talbot, G.H.; Bradley, J.S.; Edwards, J.E.; Gilbert, D.; Rice, L.B.; Scheld, M.; Spellberg, B.; Bartlett, J. Bad Bugs, No Drugs: No ESKAPE! An Update from the Infectious Diseases Society of America. Clin. Infect. Dis. 2009, 48, 1–12. [Google Scholar] [CrossRef] [PubMed]
- De Oliveira, D.M.; Forde, B.M.; Kidd, T.J.; Harris, P.N.; Schembri, M.A.; Beatson, S.A.; Paterson, D.L.; Walker, M.J. Antimicrobial Resistance in ESKAPE Pathogens. Clin. Microbiol. Rev. 2020, 33, 10-1128. [Google Scholar] [CrossRef]
- Miller, W.R.; Arias, C.A. ESKAPE pathogens: Antimicrobial resistance, epidemiology, clinical impact and therapeutics. Nat. Rev. Microbiol. 2024, 22, 598–616. [Google Scholar] [CrossRef]
- Ahuatzin-Flores, O.E.; Torres, E.; Chávez-Bravo, E. Acinetobacter baumannii, a Multidrug-Resistant Opportunistic Pathogen in New Habitats: A Systematic Review. Microorganisms 2024, 12, 644. [Google Scholar] [CrossRef]
- Antunes, L.C.; Visca, P.; Towner, K.J. Acinetobacter baumannii: Evolution of a global pathogen. Pathog. Dis. 2014, 71, 292–301. [Google Scholar] [CrossRef]
- Vrancianu, C.O.; Gheorghe, I.; Czobor, I.B.; Chifiriuc, M.C. Antibiotic Resistance Profiles, Molecular Mechanisms and Innovative Treatment Strategies of Acinetobacter baumannii. Microorganisms 2020, 8, 935. [Google Scholar] [CrossRef]
- Ramirez, M.S.; Bonomo, R.A.; Tolmasky, M.E. Carbapenemases: Transforming Acinetobacter baumannii into a Yet More Dangerous Menace. Biomolecules 2020, 10, 720. [Google Scholar] [CrossRef] [PubMed]
- Loc-Carrillo, C.; Abedon, S.T. Pros and cons of phage therapy. Bacteriophage 2011, 1, 111–114. [Google Scholar] [CrossRef] [PubMed]
- Rohde, C.; Wittmann, J.; Kutter, E. Bacteriophages: A Therapy Concept against Multi-Drug-Resistant Bacteria. Surg. Infect. 2018, 19, 737–744. [Google Scholar] [CrossRef] [PubMed]
- Gordillo Altamirano, F.L.; Barr, J.J. Phage Therapy in the Postantibiotic Era. Clin. Microbiol. Rev. 2019, 32, e00066-18. [Google Scholar] [CrossRef]
- Kapoor, A.; Mudaliar, S.B.; Bhat, V.G.; Chakraborty, I.; Prasad, A.S.; Mazumder, N. Phage therapy: A novel approach against multidrug-resistant pathogens. 3 Biotech 2024, 14, 256. [Google Scholar] [CrossRef]
- Rodriguez, J.M.; Woodworth, B.A.; Horne, B.; Fackler, J.; Brownstein, M.J. Case Report: Successful use of phage therapy in refractory MRSA chronic rhinosinusitis. Int. J. Infect. Dis. 2022, 121, 14–16. [Google Scholar] [CrossRef]
- Lebeaux, D.; Merabishvili, M.; Caudron, E.; Lannoy, D.; Simaey, L.V.; Duyvejonck, H.; Guillemain, R.; Thumerelle, C.; Podglajen, I.; Compain, F.; et al. A Case of Phage Therapy against Pandrug-Resistant Achromobacter xylosoxidans in a 12-Year-Old Lung-Transplanted Cystic Fibrosis Patient. Viruses 2021, 13, 60. [Google Scholar] [CrossRef]
- Green, S.I.; Clark, J.R.; Santos, H.H.; Weesner, K.E.; Salazar, K.C.; Aslam, S.; Campbell, J.W.; Doernberg, S.B.; Blodget, E.; Morris, M.I.; et al. A Retrospective, Observational Study of 12 Cases of Expanded-Access Customized Phage Therapy: Production, Characteristics, and Clinical Outcomes. Clin. Infect. Dis. 2023, 77, 1079–1091. [Google Scholar] [CrossRef]
- LaVergne, S.; Hamilton, T.; Biswas, B.; Kumaraswamy, M.; Schooley, R.T.; Wooten, D. Phage Therapy for a Multidrug-Resistant Acinetobacter baumannii Craniectomy Site infection. Open Forum Infect. Dis. 2018, 5, 4. [Google Scholar] [CrossRef]
- Qu, J.; Zou, J.; Zhang, J.; Qu, J.; Lu, H. Phage therapy for extensively drug resistant Acinetobacter baumannii infection: Case report and in vivo evaluation of the distribution of phage and the impact on gut microbiome. Front. Med. 2024, 11, 1432703. [Google Scholar] [CrossRef]
- Gordillo, F.; Forsyth, J.H.; Patwa, R.; Kostoulias, X.; Trim, M.; Subedi, D.; Archer, S.K.; Morris, F.C.; Oliveira, C.; Kielty, L.; et al. Bacteriophage-resistant Acinetobacter baumannii are resensitized to antimicrobials. Nat. Microbiol. 2021, 6, 157–161. [Google Scholar] [CrossRef]
- Hyman, P. Phages for Phage Therapy: Isolation, Characterization, and Host Range Breadth. Pharmaceuticals 2019, 12, 35. [Google Scholar] [CrossRef] [PubMed]
- Merabishvili, M.; Pirnay, J.P.; De Vos, D. Guidelines to Coompose an Ideal Bacteriophage Cocktail. In Bacteriophage Therapy: From Lab to Clinical Practice, 2nd ed.; Azeredo, J., Sillankorva, S., Eds.; Springer: Berlin/Heidelberg, Germany, 2024; pp. 49–57. [Google Scholar] [CrossRef]
- Turner, D.; Shkoporov, A.N.; Lood, C.; Millard, A.D.; Dutilh, B.E.; Alfenas-Zerbini, P.; Van Zyl, L.J.; Aziz, R.K.; Oksanen, H.M.; Poranen, M.M.; et al. Abolishment of morphology-based taxa and change to binomial species names: 2022 taxonomy update of the ICTV bacterial viruses subcommittee. Arch. Virol. 2023, 168, 74. [Google Scholar] [CrossRef]
- Reyneke, B.; Havenga, B.; Waso-Reyneke, M.; Khan, S.; Khan, W. Benefits and Challenges of Applying Bacteriophage Biocontrol in the Consumer Water Cycle. Microorganisms 2024, 12, 1163. [Google Scholar] [CrossRef]
- Choi, Y.J.; Kim, S.; Shin, M.; Kim, J. Isolation and Characterization of Novel Bacteriophages to Target Carbapenem-Resistant Acinetobacter baumannii. Antibiotics 2024, 13, 610. [Google Scholar] [CrossRef] [PubMed]
- Knecht, L.E.; Veljkovic, M.; Fieseler, L. Diversity and Function of Phage Encoded Depolymerases. Front. Microbiol. 2020, 10, 2949. [Google Scholar] [CrossRef]
- Vukotic, G.; Obradovic, M.; Novovic, K.; Di Luca, M.; Jovcic, B.; Fira, D.; Neve, H.; Kojic, M.; McAuliffe, O. Characterization, Antibiofilm, and Depolymerizing Activity of Two Phages Active on Carbapenem-Resistant Acinetobacter baumannii. Front. Med. 2020, 7, 426. [Google Scholar] [CrossRef] [PubMed]
- Brives, C.; Pourraz, J. Phage therapy as a potential solution in the fight against AMR: Obstacles and possible futures. Palgrave Commun. 2020, 6, 100. [Google Scholar] [CrossRef]
- Bagińska, N.; Grygiel, I.; Orwat, F.; Harhala, M.A.; Jędrusiak, A.; Gębarowska, E.; Letkiewicz, S.; Górski, A.; Jończyk-Matysiak, E. Stability study in selected conditions and biofilm-reducing activity of phages active against drug-resistant Acinetobacter baumannii. Sci. Rep. 2024, 14, 4285. [Google Scholar] [CrossRef]
- Huang, L.; Huang, S.; Jiang, L.; Tan, J.; Yan, X.; Gou, C.; Chen, X.; Xiang, L.; Wang, D.; Huang, G.; et al. Characterisation and sequencing of the novel phage Abp95, which is effective against multi-genotypes of carbapenem-resistant Acinetobacter baumannii. Sci. Rep. 2023, 13, 188. [Google Scholar] [CrossRef]
- Wintachai, P.; Naknaen, A.; Thammaphet, J.; Pomwised, R.; Phaonakrop, N.; Roytrakul, S.; Smith, D.R. Characterization of extended-spectrum-β-lactamase producing Klebsiella pneumoniae phage KP1801 and evaluation of therapeutic efficacy in vitro and in vivo. Sci. Rep. 2020, 10, 11803. [Google Scholar] [CrossRef] [PubMed]
- Colom, J.; Cano-Sarabia, M.; Otero, J.; Aríñez-Soriano, J.; Cortés, P.; Maspoch, D.; Llagostera, M. Microencapsulation with alginate/CaCO3: A strategy for improved phage therapy. Sci. Rep. 2017, 7, 41441. [Google Scholar] [CrossRef] [PubMed]
- Tan, Y.; Su, J.; Luo, D.; Liang, B.; Liu, S.; Zeng, H. Isolation and genome-wide analysis of the novel Acinetobacter baumannii bacteriophage vB_AbaM_AB3P2. Arch. Virol. 2024, 169, 66. [Google Scholar] [CrossRef] [PubMed]
- Jiang, L.; Tan, J.; Hao, Y.; Wang, Q.; Yan, X.; Wang, D.; Tuo, L.; Wei, Z.; Huang, G. Isolation and Characterization of a Novel Myophage Abp9 Against Pandrug Resistant Acinetobacater baumannii. Front. Microbiol. 2020, 11, 506068. [Google Scholar] [CrossRef]
- Wintachai, P.; Voravuthikunchai, S.P. Characterization of Novel Lytic Myoviridae Phage Infecting Multidrug-Resistant Acinetobacter baumannii and Synergistic Antimicrobial Efficacy between Phage and Sacha Inchi Oil. Pharmaceuticals 2022, 15, 291. [Google Scholar] [CrossRef]
- Orozco-Ochoa, A.K.; González-Gómez, J.P.; Quiñones, B.; Castro-del Campo, N.; Valdez-Torres, J.B.; Chaidez-Quiroz, C. Bacteriophage Indie resensitizes multidrug-resistant Acinetobacter baumannii to antibiotics in vitro. Sci. Rep. 2025, 15, 11578. [Google Scholar] [CrossRef]
- Han, K.; Zhu, Y.; Li, M.; An, X.; Song, L.; Fan, H.; Tong, Y. Genomic analysis of Acinetobacter phage BUCT629, a newly isolated member of the genus Obolenskvirus. Arch. Virol. 2022, 167, 1197–1199. [Google Scholar] [CrossRef]
- Suh, G.A.; Lodise, T.P.; Tamma, P.D.; Knisely, J.M.; Alexander, J.; Aslam, S.; Barton, K.D.; Bizzell, E.; Totten, K.M.; Campbell, J.L.; et al. Considerations for the Use of Phage Therapy in Clinical Practice. Antimicrob. Agents Chemother. 2022, 66, e0207121. [Google Scholar] [CrossRef] [PubMed]
- Evseev, P.V.; Shneider, M.M.; Kolupaeva, L.V.; Kasimova, A.A.; Timoshina, O.Y.; Perepelov, A.V.; Shpirt, A.M.; Shelenkov, A.A.; Mikhailova, Y.V.; Suzina, N.E.; et al. New Obolenskvirus Phages Brutus and Scipio: Biology, Evolution, and Phage-Host Interaction. Int. J. Mol. Sci. 2024, 25, 2074. [Google Scholar] [CrossRef]
- Love, M.J.; Abeysekera, G.S.; Muscroft-Taylor, A.C.; Billington, C.; Dobson, R.C. On the catalytic mechanism of bacteriophage endolysins: Opportunities for engineering. Biochim. Biophys. Acta Proteins Proteom. 2020, 1868, 140302. [Google Scholar] [CrossRef]
- Stojković, E.A.; Rothman-Denes, L.B. Coliphage N4 N-acetylmuramidase defines a new family of murein hydrolases. J. Mol. Biol. 2007, 366, 406–419. [Google Scholar] [CrossRef] [PubMed]
- Pei, J.; Grishin, N.V. COG3926 and COG5526: A tale of two new lysozyme-like protein families. Protein Sci. 2005, 14, 2574–2581. [Google Scholar] [CrossRef]
- Fischetti, V.A. Bacteriophage endolysins: A novel anti-infective to control Gram-positive pathogens. Int. J. Med. Microbiol. 2010, 300, 357–362. [Google Scholar] [CrossRef] [PubMed]
- Schmelcher, M.; Donovan, D.M.; Loessner, M.J. Bacteriophage endolysins as novel antimicrobials. Future Microbiol. 2012, 7, 1147–1171. [Google Scholar] [CrossRef]
- González-Gómez, J.P.; Rodríguez-Arellano, S.N.; Gomez-Gil, B.; Vergara-Jiménez, M.D.; Chaidez, C. Genomic and biological characterization of bacteriophages against Enterobacter cloacae, a high-priority pathogen. Virology 2024, 595, 110100. [Google Scholar] [CrossRef]
- Jamalludeen, N.; Johnson, R.P.; Friendship, R.; Kropinski, A.M.; Lingohr, E.J.; Gyles, C.L. Isolation and characterization of nine bacteriophages that lyse O149 enterotoxigenic Escherichia coli. Vet. Microbiol. 2007, 124, 47–57. [Google Scholar] [CrossRef]
- González-Gómez, J.; González-Torres, B.; Guerrero-Medina, P.J.; López-Cuevas, O.; Chaidez, C.; Avila-Novoa, M.G.; Gutiérrez-Lomelí, M. Efficacy of Novel Bacteriophages against Escherichia coli. Antibiotics 2021, 10, 1150. [Google Scholar] [CrossRef]
- Asghar, S.; Ahmed, A.; Khan, S.; Lail, A.; Shakeel, M. Genomic characterization of lytic bacteriophages, A¥L and A¥M infecting ESBL K. pneumoniae and its therapeutic potential on biofilm dispersal and in-vivo bacterial clearance. Microbiol. Res. 2022, 262, 127104. [Google Scholar] [CrossRef]
- Capra, M.L.; Quiberoni, A.; Reinheimer, J. Phages of Lactobacillus casei/paracasei: Response to environmental factors and interaction with collection and commercial strains. J. Appl. Microbiol. 2006, 100, 334–342. [Google Scholar] [CrossRef] [PubMed]
- Kropinski, A.M. Practical Advice on the One-Step Growth Curve. Methods Mol. Biol. 2018, 1681, 41–47. [Google Scholar] [CrossRef] [PubMed]
- Kim, M.K.; Chen, Q.; Echterhof, A.; Pennetzdorfer, N.; McBride, R.C.; Banaei, N.; Burgener, E.B.; Milla, C.E.; Bollyky, P.L. A blueprint for broadly effective bacteriophage-antibiotic cocktails against bacterial infections. Nat. Commun. 2024, 15, 9987. [Google Scholar] [CrossRef] [PubMed]
- Pickard, D.J. Preparation of Bacteriophage Lysates and Pure DNA. In Bacteriophages: Methods and Protocols, Volume 2: Molecular and Applied Aspects, 1st ed.; Clokie, M.R., Kropinski, A.M., Eds.; Springer: Totowa, NJ, USA, 2009; pp. 3–9. [Google Scholar] [CrossRef]
- Chen, S. Ultrafast one-pass FASTQ data preprocessing, quality control, and deduplication using fastp. iMeta 2023, 2, e107. [Google Scholar] [CrossRef]
- Chen, S.; Zhou, Y.; Chen, Y.; Gu, J. fastp: An ultra-fast all-in-one FASTQ preprocessor. Bioinformatics 2018, 34, i884–i890. [Google Scholar] [CrossRef]
- Prjibelski, A.; Antipov, D.; Meleshko, D.; Lapidus, A.; Korobeynikov, A. Using SPAdes De Novo Assembler. Curr. Protoc. Bioinform. 2020, 70, e102. [Google Scholar] [CrossRef]
- Bouras, G.; Nepal, R.; Houtak, G.; Psaltis, A.J.; Wormald, P.J.; Vreugde, S. Pharokka: A fast scalable bacteriophage annotation tool. Bioinformatics 2023, 39, btac776. [Google Scholar] [CrossRef] [PubMed]
- Laslett, D.; Canback, B. ARAGORN, a program to detect tRNA genes and tmRNA genes in nucleotide sequences. Nucleic Acids Res. 2004, 32, 11–16. [Google Scholar] [CrossRef]
- Chen, L.; Yang, J.; Jun, Y.; Yao, Z.; Sun, L.; Shen, Y.; Jin, Q. VFDB: A reference database for bacterial virulence factors. Nucleic Acids Res. 2005, 33, D325–D328. [Google Scholar] [CrossRef]
- McArthur, A.G.; Waglechner, N.; Nizam, F.; Yan, A.; Azad, M.A.; Baylay, A.J.; Bhullar, K.; Canova, M.J.; De Pascale, G.; Ejim, L.; et al. The Comprehensive Antibiotic Resistance Database. Antimicrob. Agents Chemother. 2013, 57, 3348–3357. [Google Scholar] [CrossRef]
- Feldgarden, M.; Brover, V.; Gonzalez-Escalona, N.; Fryer, J.G.; Haendiges, J.; Haft, D.H.; Hoffmann, M.; Pettengill, J.B.; Prasad, A.B.; Tillman, G.E.; et al. AMRFinderPlus and the Reference Gene Catalog facilitate examination of the genomic links among antimicrobial resistance, stress response, and virulence. Sci. Rep. 2021, 11, 12728. [Google Scholar] [CrossRef] [PubMed]
- Tynecki, P.; Guziński, A.; Kazimierczak, J.; Jadczuk, M.; Dastych, J.; Onisko, A. PhageAI—Bacteriophage Life Cycle Recognition with Machine Learning and Natural Language Processing. bioRxiv 2020. [Google Scholar] [CrossRef]
- Moraru, C.; Varsani, A.; Kropinski, A.M. VIRIDIC—A Novel Tool to Calculate the Intergenomic Similarities of Prokaryote-Infecting Viruses. Viruses 2020, 12, 1268. [Google Scholar] [CrossRef]
- Gilchrist, C.L.M.; Chooi, Y.H. Clinker & clustermap.js: Automatic generation of gene cluster comparison figures. Bioinformatics 2021, 37, 2473–2475. [Google Scholar] [CrossRef]
- Mirdita, M.; Schütze, K.; Moriwaki, Y.; Heo, L.; Ovchinnikov, S.; Steinegger, M. ColabFold: Making protein folding accessible to all. Nat. Methods 2022, 19, 679–682. [Google Scholar] [CrossRef]
- Blum, M.; Andreeva, A.; Florentino, L.C.; Chuguransky, S.R.; Grego, T.; Hobbs, E.; Pinto, B.L.; Orr, A.; Paysan-Lafosse, T.; Ponamareva, I.; et al. InterPro: The protein sequence classification resource in 2025. Nucleic Acids Res. 2025, 53, D444–D456. [Google Scholar] [CrossRef]
- Lau, A.M.; Bordin, N.; Kandathil, S.M.; Sillitoe, I.; Waman, V.P.; Wells, J.; Orengo, C.A.; Jones, D.T. Exploring structural diversity across the protein universe with The Encyclopedia of Domains. Science 2024, 386, eadq4946. [Google Scholar] [CrossRef]

| Strain | Code | Source | Spot Assay | EOP |
|---|---|---|---|---|
| A. baumannii | A089 | Peritoneal fluid | - | - |
| A. baumannii | A103 | Urine | - | - |
| A. baumannii | A048 | Lung aspirate | - | - |
| A. baumannii | A045 | Endotracheal aspirate | - | - |
| A. baumannii | A063 | Surgical wound | - | - |
| A. baumannii | A137 | Sputum | - | - |
| A. baumannii | A052 | Endotracheal aspirate | - | - |
| A. baumannii | A062 | Urine | - | - |
| A. baumannii | A038 | Sputum | - | - |
| A. baumannii | A007 | Blood culture | - | - |
| A. baumannii | A064 | Urine | - | - |
| A. baumannii | A095 | Blood culture | - | - |
| A. baumannii | A071 | Endotracheal aspirate | - | - |
| A. baumannii | A098 | Endotracheal aspirate | - | - |
| A. baumannii | A056 | Blood culture | - | - |
| A. baumannii | A067 | Endotracheal aspirate | - | - |
| A. baumannii | A075 | Endotracheal aspirate | + | ++ (1.00) |
| A. baumannii | A019 | Urine | + | ++ (0.78) |
| A. baumannii | A069 | Urine | - | - |
| S. aureus | ATCC 6538 | Human lesion | - | - |
| S. aureus | ATCC 25923 | Clinical isolate | - | - |
| E. coli | ATCC 11303 | Not described | - | - |
| S. enterica | ATCC 10708 | Not described | - | - |
| P. aeruginosa | ATCC 15442 | Water bottle | - | - |
| L. monocytogenes | ATCC 19111 | Poultry | - | - |
Disclaimer/Publisher’s Note: The statements, opinions and data contained in all publications are solely those of the individual author(s) and contributor(s) and not of MDPI and/or the editor(s). MDPI and/or the editor(s) disclaim responsibility for any injury to people or property resulting from any ideas, methods, instructions or products referred to in the content. |
© 2025 by the authors. Licensee MDPI, Basel, Switzerland. This article is an open access article distributed under the terms and conditions of the Creative Commons Attribution (CC BY) license (https://creativecommons.org/licenses/by/4.0/).
Share and Cite
Vera-Jauregui, E.; Avila-Novoa, M.G.; González-Torres, B.; Guerrero-Medina, P.J.; Chaidez, C.; González-López, I.; González-Gómez, J.P.; Gutiérrez-Lomelí, M. A Newly Discovered Obolenskvirus Phage with Sustained Lytic Activity Against Multidrug-Resistant Acinetobacter baumannii. Antibiotics 2025, 14, 961. https://doi.org/10.3390/antibiotics14100961
Vera-Jauregui E, Avila-Novoa MG, González-Torres B, Guerrero-Medina PJ, Chaidez C, González-López I, González-Gómez JP, Gutiérrez-Lomelí M. A Newly Discovered Obolenskvirus Phage with Sustained Lytic Activity Against Multidrug-Resistant Acinetobacter baumannii. Antibiotics. 2025; 14(10):961. https://doi.org/10.3390/antibiotics14100961
Chicago/Turabian StyleVera-Jauregui, Eduardo, María Guadalupe Avila-Novoa, Berenice González-Torres, Pedro Javier Guerrero-Medina, Cristobal Chaidez, Irvin González-López, Jean Pierre González-Gómez, and Melesio Gutiérrez-Lomelí. 2025. "A Newly Discovered Obolenskvirus Phage with Sustained Lytic Activity Against Multidrug-Resistant Acinetobacter baumannii" Antibiotics 14, no. 10: 961. https://doi.org/10.3390/antibiotics14100961
APA StyleVera-Jauregui, E., Avila-Novoa, M. G., González-Torres, B., Guerrero-Medina, P. J., Chaidez, C., González-López, I., González-Gómez, J. P., & Gutiérrez-Lomelí, M. (2025). A Newly Discovered Obolenskvirus Phage with Sustained Lytic Activity Against Multidrug-Resistant Acinetobacter baumannii. Antibiotics, 14(10), 961. https://doi.org/10.3390/antibiotics14100961

